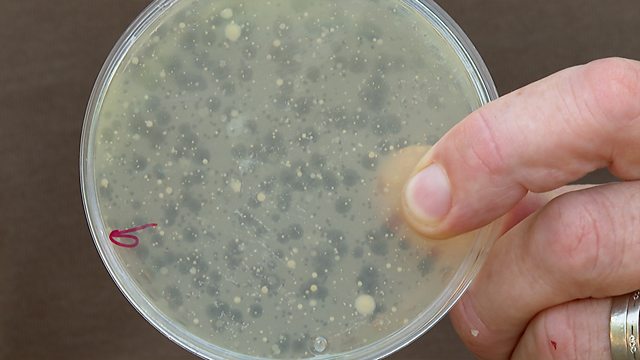

Main content
蜜芽传媒 Lingohack “英语大破解”:Could zoo poo hold the key to fighting infection? 动物园动物的粪便能为我们带来对抗感染的解药吗?
Practise your English listening skills with this story
Duration:
This clip is from
More clips from 蜜芽传媒 Learning English
-
![]()
蜜芽传媒 Q&A of the Week “你问我答”:搭配 “all but” 的用法
Duration: 04:51
-
![]()
蜜芽传媒 Phrasal verbs for travel:与 “旅行” 相关的短语动词
Duration: 02:14
-
![]()
蜜芽传媒 Authentic Real English “地道英语”:Neck of the woods 这个区域,这一带
Duration: 02:42





